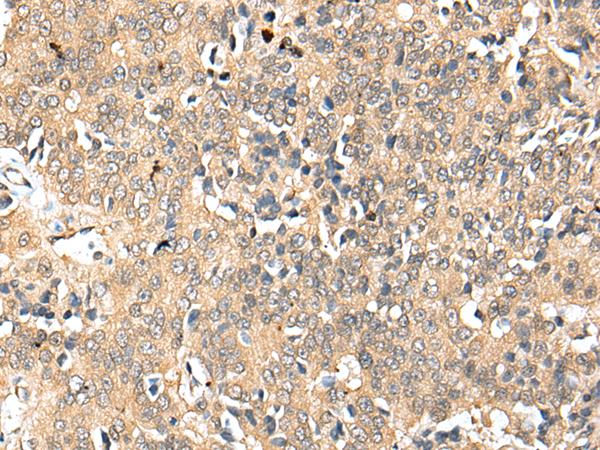
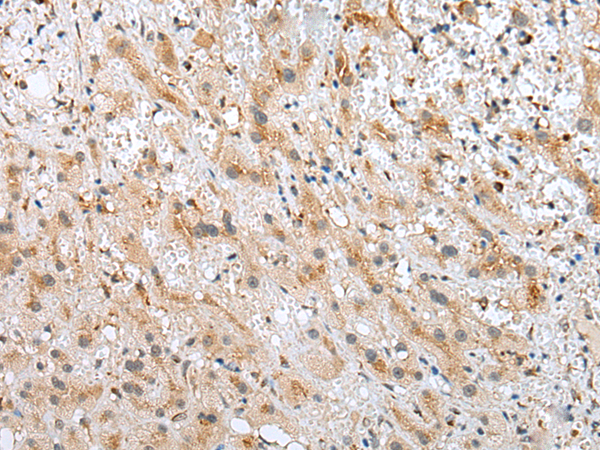
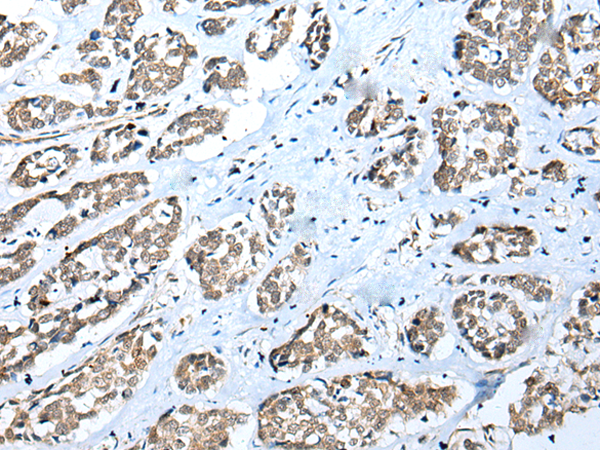

-
分类: 科研抗体货号: P09112别名: CFM2; FAM101A应用: IHC反应种属: Human
-
分类: 科研抗体货号: P09096别名:应用: IHC反应种属: Human
-
分类: 科研抗体货号: P09110别名: RCDG1应用: IHC反应种属: Human
-
分类: 科研抗体货号: P09095别名: C8C应用: WB,IHC反应种属: Human
-
分类: 科研抗体货号: P09109别名: THEG2; C22orf41应用: IHC反应种属: Human, Mouse
-
分类: 科研抗体货号: P09094别名: NCUBE2; NCUBE-2; PRO2121应用: WB,IHC反应种属: Human, Mouse
-
分类: 科研抗体货号: P09108别名: RIG; S15应用: WB反应种属: Human, Mouse, Rat
-
分类: 科研抗体货号: P09093别名: KAZ应用: IHC反应种属: Human, Mouse, Rat
-
分类: 科研抗体货号: P09107别名: FUCU; FucM; C10orf125应用: IHC反应种属: Human, Mouse
-
分类: 科研抗体货号: P09092别名: ICB-1; C1orf38应用: IHC反应种属: Human

鄂公网安备42018502007531号
鄂公网安备42018502007531号

